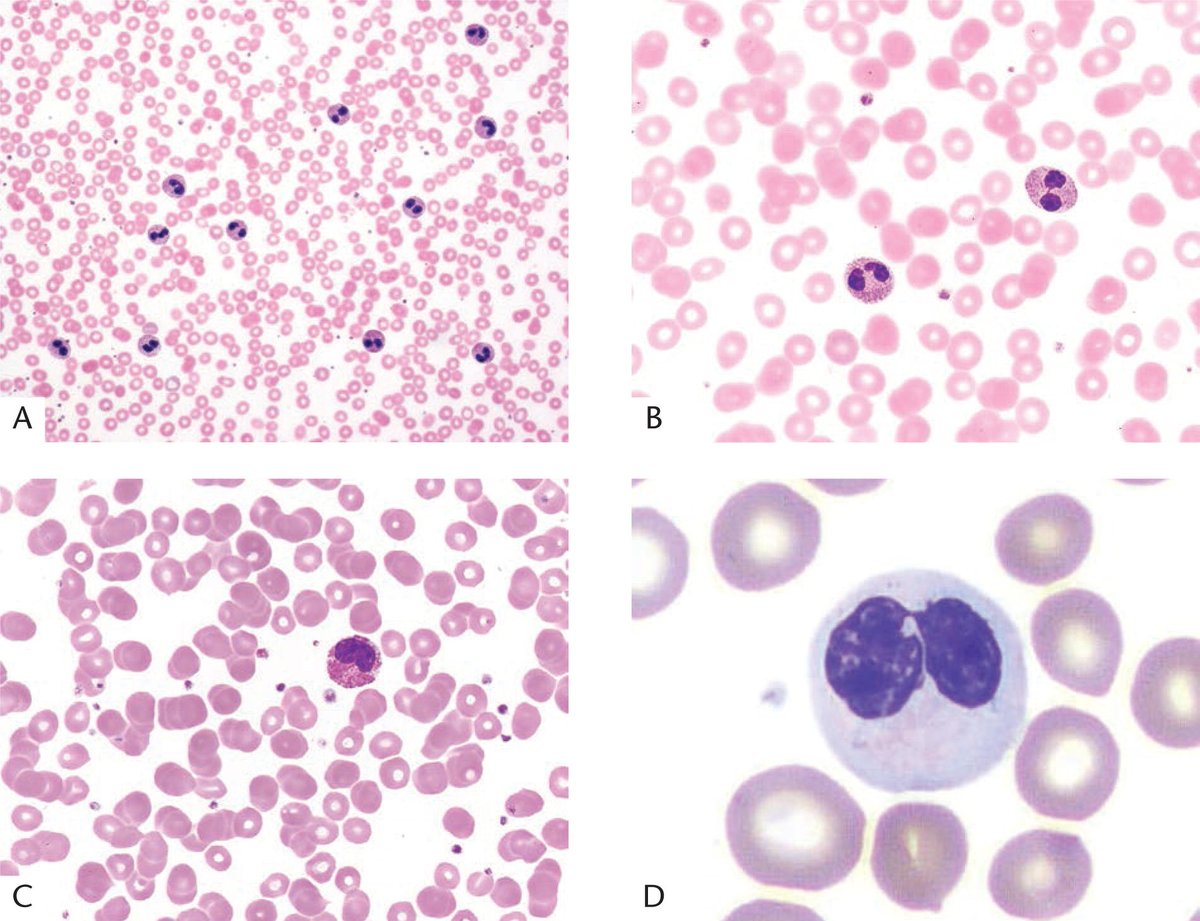
ARP Press tweet media

More from the non neoplastic bone marrow fascicle (arppress.org/books/book/71):
Pelger-Huët syndrome (or anomaly) is due to mutations in the laminin beta receptor gene, which results in an abnormal nuclear morphology of segmented neutrophils (incidence of approximately 1 in 10,000 individuals).
#HemePath
English






















